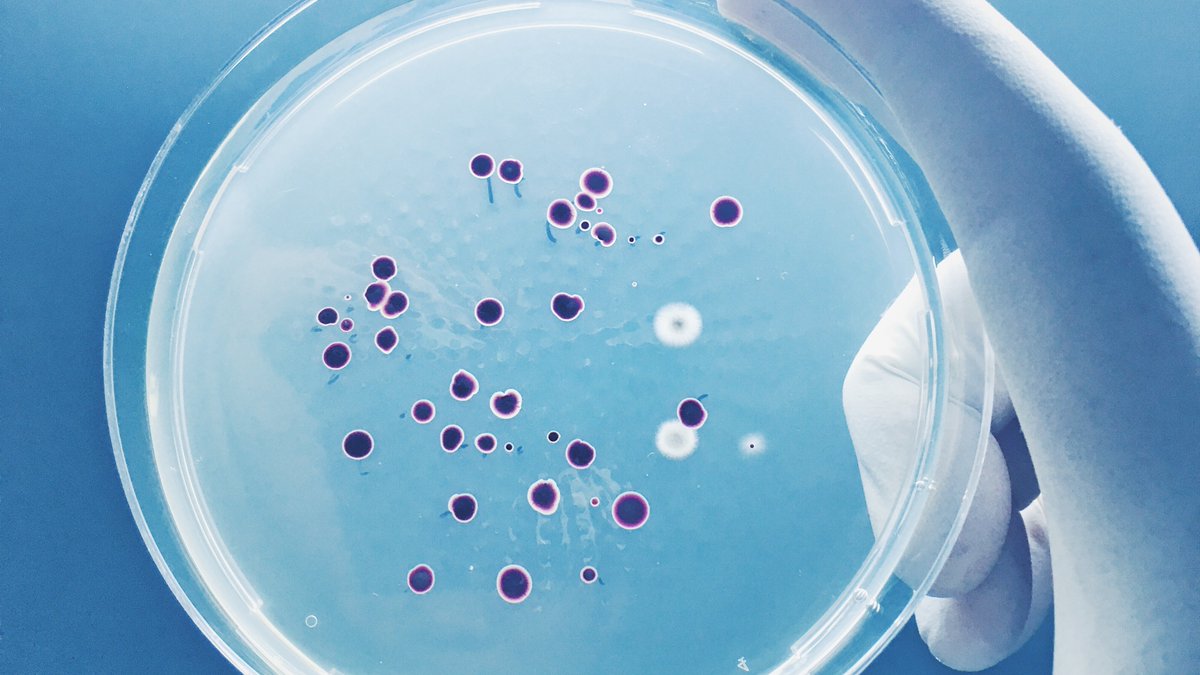

LicciardiLab
@licciardilab
ID: 1441315247877287950
24-09-2021 08:16:13
102 Tweet
54 Takipçi
158 Takip Edilen

Excited our inaugural PROPHECY symposium has started. First session is kicking off with Prof Kanta Subbarao WHO CC Influenza Melbourne who is sharing outcomes of the DISCOVER-HCP study. #PROPHEC19


July Special Issue: Systems Immunology II Trends in Immunology Cell Press: #macrophage #signaling; #microbiome conditions #immunesystem; #tolerance & #CTL memory, #transcription factor #variegation, CTL #aging, #multiscale topology of immune responses & more cell.com/trends/immunol…




Excited to share this work, led by Sam Manna with Markus Hilty, Joel & Neil, together with Stephanie Lo LicciardiLab @BelindaOrtika Eliza Fiona Russell Kim Mulholland Eileen Dunne & many more not on twitterX especially our colleagues Drs Odgerel & Tuya #Mongolia



MCRI's Daniel Pellicci has been awarded a Viertel Senior Medical Research Fellowship. This #research could help reduce the severity of #Tuberculosis, #StrepA and #RSV - and pave the way for future #vaccines. Read more👉mcri.edu.au/news/awards/fe…

Now hiring to a project officer role for the PROPHECY study. Large MRFF funded clinical and scientific collaboration studying COVID vaccine responses in high risk populations.PROPHECY Study livehire.com/job/alfredheal… monash.edu/medicine/proph…

The Melbourne Vaccine Education Centre is inviting healthcare professionals to join an upcoming clinical vaccinology update on RSV at The Royal Children's Hospital, Melbourne on June 21. | #MCRI #RSV #Vaccination #InfectiousDisease Melbourne Vaccine Education Centre (MVEC) Register ➡️ mvec.mcri.edu.au/events/cvu-min…


Our recent preprint by postdoc Nadia Mazarakis is out on evaluation of SARS-CoV-2 antibody responses in adults and children using a novel microsampling device doi.org/10.1101/2024.0… Great to have the collaboration with Trajan Synexa Life Sciences Murdoch Children's Research Institute (MCRI) Ryan Toh

A new #MCRI led study has found that fewer doses of #pneumococcal vaccines were just as effective at providing sustained immunity among Vietnamese babies. Menzies Research Darren S Ong LicciardiLab Thanh Phan Ryan Toh Kim Mulholland 👉 nature.com/articles/s4146…


Our NHMRC CRE developed a new collaboration with Faculty of Medicine Siriraj Hospital, Mahidol U. Thailand Our 2 vs 3 PCV dose noninferiority RCT using the more affordable SerumInstituteIndia has recruited 100 in 3w 🎉 LicciardiLab Catherine Satzke Murdoch Children's Research Institute (MCRI)


Respiratory syncytial virus (RSV) is a major cause of illness and death in infants and older adults. A Review in The Lancet Infectious Diseases discusses the different RSV vaccines available and emphasizes the need to ensure these vaccines reach the most vulnerable: hubs.li/Q030TKl10



Our latest research on single dose #HPV vaccination just published Nature Communications -supports one dose strategy using systems serology rdcu.be/eb1cs Great team science Ryan Toh Amy Chung and our PhD student Chau Quang and everyone else involved Murdoch Children's Research Institute (MCRI) University of Melbourne



One dose of the human papillomavirus (HPV) #vaccine is just as effective in providing long-term immune protection against #cervicalcancer as a two or three dose schedule, a new #MCRI-led study finds. 👉 nature.com/articles/s4146… LicciardiLab Ryan Toh Chau Quang


In 2024, nearly 38 million children under five were acutely malnourished across 26 nutrition crises. “We cannot respond to empty stomachs with empty hands and turned backs.” - António Guterres Learn more. ⬇️


